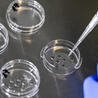
Bio&eacute;thique & Procr&eacute;ation

La technique, vertigineuse, est prête : deux équipes viennent d’annoncer avoir réussi à façonner un embryon humain jusqu’à 14 jours, limite permise par la loi, dans une boite de Pétri, à partir de cellules souches.
Follow, research and publish the best content
Get Started for FREE
Sign up with Facebook Sign up with X
I don't have a Facebook or a X account
Already have an account: Login
A l’origine des questions bioéthiques se trouvent de grandes souffrances humaines : épreuve de l’infertilité, du handicap….
Curated by
Alliance VITA
 Your new post is loading... Your new post is loading...
 Your new post is loading... Your new post is loading...
|
|